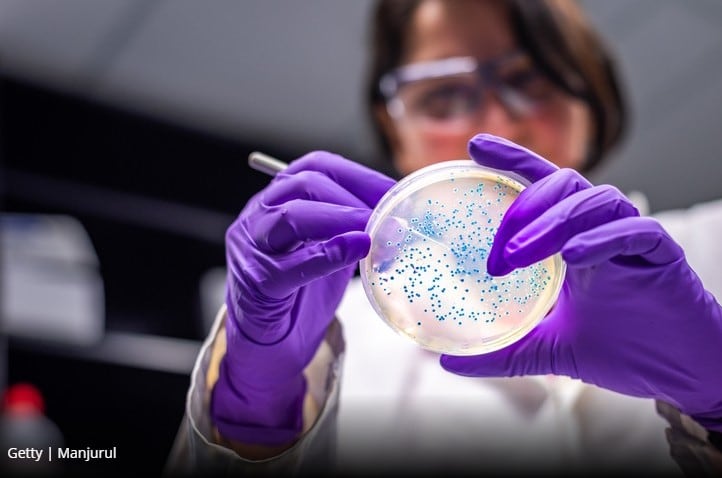
Team puts forward FMT insight into its success against C. difficile infection

Supplement's anti aging benefits confirmed via DNA methylation measurement
A dietary supplement based on CaAKG (calcium alpha-ketoglutarate) reduced biological age as measured by a DNA test, according to a recently published study.

A dietary supplement based on CaAKG (calcium alpha-ketoglutarate) reduced biological age as measured by a DNA test, according to a recently published study.

Franchise sports nutrition retailer Nutrishop has announced a new immune health offering while it also makes progress on its store-within-a-gym concept.

Increased focus on self-care and wellbeing, a desire to find back joy and push forward with the green agenda are just some of the key trends set to shape the European, Middle East & African beauty market next year – here are our Top 5 EMEA trends to watch.

A combination of omega-3 fatty acids, lutein, meso-zeaxanthin, and zeaxanthin, and vitamin E may improve working memory in cognitively healthy older adults, says a new study from Ireland.

The oral availability of ginger extracts may be boosted by using a krill oil-based self-emulsifying drug delivery system (SEDDS), says a new study from Japan.

The European Commission (EC) rounds off this month and this year with a few last-minute additions to the Novel Food register as a mushroom powder and boron source for supplements all make the grade.
Researchers have proposed a more detailed explanation as to why faecal microbial transplants (FMT) from a healthy donor can improve outcomes in patients with Clostridioides difficile infection (CDI).

Lactalis Ingredients has officially inaugurated a new whey drying tower at its Verdun site in France. The facility now has a production capacity of 30,000 tonnes, allowing the dairy and ingredients supplier to expand into new markets.

Vietnamese consumers preferred vitamins and minerals supplements (VMS) rather than traditional Vietnamese herbal products, when asked what they would use to aid COVID-19 prevention or treatment, a new survey has found.

Here are our top 10 trends stories APAC’s health and nutrition industry this year, spanning the NMN craze, halal products, and e-commerce strategy.

See our top 10 most read nutrition research studies on APAC’s health and nutrition industry this year, featuring clinical trials on omega-3, amino acids, probiotics and more.

Australia’s complementary medicines industry is “in a good position” compared to many other countries when it comes to meeting China’s new customs regulations which will kick in next January, says a leading figure at the Therapeutic Goods Administration...

South Korea has introduced an ‘S mark’ certification for food products that have undergone review and been approved as elderly-friendly, with products for the ageing population being dubbed a ‘future food’ category for the country.